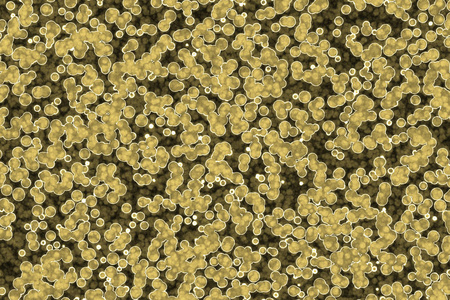
细菌细胞形态:球菌杆菌螺旋菌背景照片

球菌杆菌螺旋菌

细菌细胞形态:球菌杆菌螺旋菌背景照片
图片尺寸450x300
课件1(生物北师大版八年级上册) (一)细菌 球菌 杆菌 螺旋菌
图片尺寸1080x810
我们爱科学_人体_球菌_杆菌
图片尺寸1080x720
八年级生物 球菌 杆菌 螺旋菌
图片尺寸1080x810
细菌按形态分类: 球菌 螺旋菌 杆菌
图片尺寸1080x810
10种20种25种50种细菌微生物玻片革兰染色球菌杆菌螺旋菌生物教学
图片尺寸1000x1000
幽门螺杆菌# 是存在于胃及十二指肠球部的一种螺旋状细菌,该细菌为
图片尺寸2073x1280
细菌细胞形态:球菌杆菌螺旋菌背景照片
图片尺寸450x300
幽 门 螺 旋 杆 菌 螺旋菌 葡萄球菌 大肠杆菌
图片尺寸1080x810
革兰染色细菌微生物玻片10种25种50种高教标准制作球菌杆菌螺旋菌
图片尺寸750x488
细菌细胞形状球菌杆菌螺旋菌背景
图片尺寸1024x683
又称 a target="_blank" href="/item/幽门螺杆菌/1226672" data
图片尺寸326x250
螺旋菌 | 幽门螺杆菌 | 幽门螺旋菌(螺旋状细菌)
图片尺寸352x352
三类细菌 葡萄球菌(30000x) 枯草杆菌(3738x) 迂回螺菌(2295x)
图片尺寸1080x810
自己精心编排,集合了众多ppt的优点 细菌的形态 球菌 杆菌 弧菌 螺旋
图片尺寸1080x810
杆菌:__________________;球菌:___________________;螺旋菌
图片尺寸328x162
菌体形态:球菌,杆菌,螺旋菌
图片尺寸450x300
细菌细胞形态:球菌,杆菌,螺旋体细菌图片
图片尺寸800x533
不同形态的细菌 杆菌 球菌 螺旋菌 弧形菌
图片尺寸1080x810
菌体形态:球菌,杆菌,螺旋菌
图片尺寸329x219